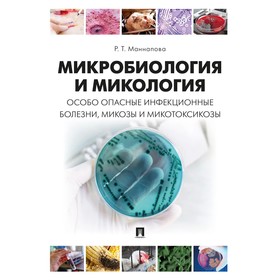
Микробиология и микология. Особо опасные инфекционные болезни, микозы и микотоксикозы. Маннапова Р.Т.

Летний костюм для мальчиков в стиле хип-хоп, черная футболка с коротким рукавом и шорты, комплект из 2 предметов, детская свободная Спортивная одежда для подростков 4, 6, 8, 10, 12, 14 лет
Price history chart & currency exchange rate
Customers also viewed

$8.45
Детские уличные игрушки, набор для гольф-клуба, мини-клубы, Повседневные детские пластиковые игрушки для игр
aliexpress.ru
$1,139.20
Компактный гусеничный гидравлический мини-экскаватор, 900 кг, Высококачественная Бытовая многофункциональная техника
aliexpress.ru
$1.61
Правая бежевая ручка из АБС-пластика для регулировки внутреннего сиденья автомобиля, ручка для регулировки заднего сиденья у правого пассажира для Chevrolet
aliexpress.ru
$33.52
Инструмент для дымохода на древесном угле, быстрое зажигание на угле, уличный стеллаж для барбекю, металлический инструмент для гриля на открытом воздухе, пикника, гриля
aliexpress.ru
$49.06
2023 Sexy Long Sleeve Shirt 2 Piece Sets Lace Up Women Tops Blouse And Loose High Waist Shorts Suit Fashion Casual Outfits
aliexpress.com
$121.10
Новая трубчатая дистилляционная Колонка 1,5 дюйма 2 дюйма с нижним зажимом, медная сетка, пивоваренное оборудование Moonshine, саморегулируемый аппарат
aliexpress.com
$808.33
White Tea Coffee Table Sets Living Room Center Accent Mini Marble Coffee Table Sets Luxury Conjunto De Muebles Hotel Furniture
aliexpress.com
$27.71
4-приводной шаговый двигатель Nema17, 42 двигателя, экструдер, Шестеренчатый шаговый двигатель, соотношение 5,18: 1, планетарный редуктор Nema 17 17HS4401
aliexpress.com
$33.75
New Chinese style blue velvet hairpin, bridal headdress robe, cheongsam, classical wedding accessories
aliexpress.com
$27.67
Hooks Christmas Stocking Hook Christmas Ornament Tree Fireplace Hook Ornament Christmas Hook
aliexpress.com
$22.55
Car Cleaning Brush Durable Car Wash Brush With Long Handle Car Cleaning Telescopic Brush Kit Car Cleaning Kit For Car Truck RV
aliexpress.com
$13.27
1Set Oil Pump Manual Portable Hand Siphon Tube Car Hose Liquid Gas Transfer Sucker Suction Inflatable Pump Universal Tools Set
aliexpress.com
$17.94
Мраморная игрушка-трек, 142 шт., прочный развивающий набор для строительства, безопасный Игровой Набор для строительства, для улучшения качес...
aliexpress.ru
$2.30
Креативный крючок для сумки различные стили декоративный крючок для сумки Простота в использовании картина-бабочка искусственный крючок
aliexpress.ru
$4.65
Набор инструментов для гравировки из углеродистой стали с деревянной ручкой, 4 шт.
aliexpress.ru
$3.61
Копия 315 Дубликатор черная электрическая вращающаяся дверь 433 Универсальный Открыватель ворот дистанционное управление для гаражной двери...
aliexpress.ru
$19.00
ЧПУ Задний амортизатор регулируемое опускание звено комплект для Honda CBR500R 2013-2016 CB500F CB500X 2013-2015 подвеска опускание звено
aliexpress.com
$4.12
Blue Red 1m×2m Laser Rain Curtain Birthday Party Wedding Stage Background Wall Decoration Colorful Aluminum Foil Tassel Supplies
aliexpress.com
$28.43
Математика 4 класс. Учебник. В 2-х частях. Издание 13-е, переработанное. Моро М.И., Бантова М.А., Бельтюкова Г.В.
sima-land.ru
$11.91
Little Middle Child Mesh Fashion Polka-dot Gauze Girl Velcro Princess Low Top Hollow Low-top Pumps
us.wholee.sale
$136.00
Hikvision IP Camera 8MP 4K POE DS-2CD2183G0-IU H.265+ 120 dB true WDR Built-in mic IR30M indoor Network Dome security Camera
aliexpress.com
$93.45
60W 4000rpm Lab Centrifuge Lower-Speed Desktop Timing Laboratory Centrifugal Machine PRP Serum Isolate Speed Control EU Plug
aliexpress.com
$7.48
Микробиология и микология. Особо опасные инфекционные болезни, микозы и микотоксикозы. Маннапова Р.Т.
sima-land.ru
$12.57
K5 Motorcycle Helmet Anti Fog Film for AGV K5 K3SV K1 Helmets Visor Anti Fog Sticker Full Face Motorcycle Helmet Accessories
aliexpress.com
$22.17
women boydcon bodysuit turtleneck streetwear club outfits body rompers womens jumpsuit cotton reflective letter long sleeve, Black;white
dhgate.com
$2.63
дышащие солнцезащитный ear многофункциональная маска для цифровой печати открытого езда triangle мужской prective маски # 748, Black
dhgate.com
$39.66
friends tv show 25th anniversary women t shirt thanksgiving day harajuku t shirt fashion fans gift fashion plus size, White
dhgate.com
$7.56
компактное косметическое зеркало ручной макияж объектив светодиодный usb зарядки сенсорное сенсорное коммутатор зеркала портативный разум ск
dhgate.com
$33.02
новые собаки kawaii забавный мультфильм футболка женщины harajuku ullzang 90s футболка гранж графическая милая футболка корейский стиль верш, White
dhgate.com
$13.55
16см фарфоровая кукла итальянский эрос triangel кукла для детей подарок на день рождения игрушка #1
dhgate.com
$8.00
For Game boy advance Label Sticker For GameBoy GBA GBC GBP GBA SP Console Back Tag
aliexpress.com
$42.90
Cartoon Animal Dog/Cat/Swan/Rabbit Pattern Doormat Children Room Rug Non-slip Breathable Living Room Bedroom Carpet
aliexpress.com
$91.14
DOM top brand quartz watch for lovers business leather couple watches luxury waterproof style reloj Square clock M-289+G-1089
aliexpress.com

















